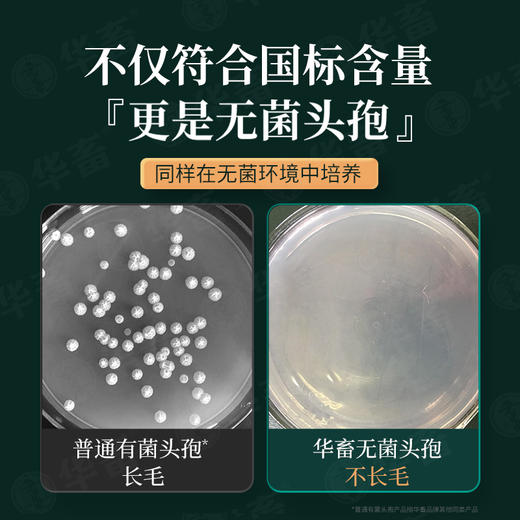
【产后康】整套立省28元 头孢*1+鱼腥草*5 产后消炎产后保健猪牛羊用 商品图3

【产后康】整套立省28元 头孢*1+鱼腥草*5 产后消炎产后保健猪牛羊用
¥69.99
| 运费: | ¥ 0.00-999.00 |
| 库存: | 4996 件 |
商品详情






- 华畜官方微信旗舰店 (微信公众号认证)
- 扫描二维码,访问我们的微信店铺
- 随时随地的购物、客服咨询、查询订单和物流...